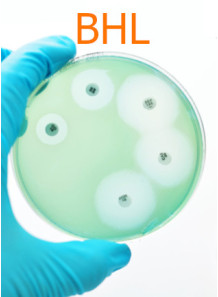
Preserve-Free BHL™

Preservative-free
Preservative-free ingredients that act as preservative
Glyceryl Caprylate
It has the characteristics of a co-emulsifier. Helps the formula have higher stability, helps dissolve ingredients (solvent) and acts as a gentle preservative. Doesn't irritate the skin. No dangerous substances It also has the characteristics of a humectant, helping to retain moisture in the skin.
Mild Preserved SC10™ (Preservative-Free)
Contains Ethylhexylglycerin and Caprylyl Glycol is a highly effective preservative but is gentle and does not irritate the skin. No dangerous substances No carcinogens It also has the characteristics of a humectant, helping to retain moisture in the skin. and is not classified as a preservative. According to FDA regulations.
Cart
No products
Subtotal:
0.00
Total
0.00
THB